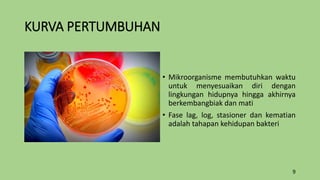
KURVA PERTUMBUHAN
• Mikroorganisme membutuhkan waktu
untuk menyesuaikan diri dengan
lingkungan hidupnya hingga akhirnya
berkembangbiak dan mati
• Fase lag, log, stasioner dan kematian
adalah tahapan kehidupan bakteri
9

Dokumen tersebut membahas tentang sterilisasi termal sebagai metode untuk mematikan mikroorganisme yang tidak diinginkan pada produk kaleng. Proses sterilisasi menggunakan panas untuk mencapai keadaan steril. Kemasan hermetis digunakan untuk menjaga produk tetap steril selama distribusi. Bakteri Clostridium merupakan target utama sterilisasi karena mampu membentuk spora yang tahan panas.